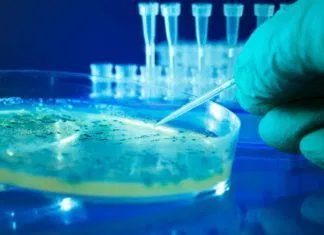

Khi nói về ớt, chắc hẳn ai trong chúng ta cũng đều nghĩ đến một loại trái cây nhỏ nhắn, có vị cay thường được dùng trong bữa ăn hằng ngày của mỗi gia đình. Tuy nhiên, trên thế giới vẫn tồn tại những giống ớt cực kỳ độc đáo mà chưa chắc bạn đã từng nhìn thấy. Hôm nay, chuyên mục độc-lạ của Bloganchoi sẽ giới thiệu với các bạn 5 giống ớt đặc biệt này nhé!
1.Giống ớt có hình dạng đặc biệt nhất thế giới

Đây là một giống ớt lạ mà chắc hẳn các chị em phụ nữ chúng ta đều phải đỏ mặt khi nhìn thấy nó. Hình dạng của quả ớt này chẳng khác nào “của quý” của nam giới và luôn được liệt kê vào một trong những loại củ quả có hình thù kỳ lạ nhất thế giới. Giống ớt này có tên thông thường là Willy và tên khoa học là Capsicum annuum var, nó còn được biết đến với tên gọi là ớt Peter còn ở Việt Nam thì người ta thường gọi đây là ớt “cu tí”. Những quả ớt “cu tí” có mùi thơm nhẹ, ít cay và rất dễ ăn, tuy nhiên giống ớt này chỉ thường được trồng để làm cảnh thay vì làm thực phẩm
2. Giống ớt dài nhất thế giới

Giống ớt này có tên là Cayenne và xuất xứ từ Trung quốc. Đây là loại ớt cho năng suất rất cao nên thường được trồng nhiều trong các nông trại, mỗi quả ớt đạt độ dài cực đại từ 30 đến 35 cm. Ớt Cayenne có màu vàng, màu tím và phổ biến nhất là màu xanh và màu đỏ. Loại ớt này có khả năng sinh trưởng rất nhanh, mật độ cho quả cao, thời gian thu hoạch lại dài đem lại lợi nhuận rất lớn cho người trồng.
3. Giống ớt có nhiều màu

Loại ớt này có xuất xứ từ Nga, hiện đang rất “hot” trong thị trường và được các chị em phụ nữ ưa thích. Nó không chỉ dùng làm gia vị trong bữa cơm gia đình mà còn là một loại cây kiểng bắt mắt. Trên mỗi cây ớt có thể cho ra 3-5 màu quả khác nhau, quả lại nhiều, mọc chi chít rất đẹp.
4. Giống ớt cay nhất thế giới

Khi nói về kỷ lục của độ cay phải nhắc đến giống ớt Naga Viper, nếu người bình thường ăn hết một quả có thể gây bỏng niêm mạc đường tiêu hóa. Độ cay của giống ớt này lên đến 1,359,000 đơn vị cay (scoville), trong khi mỗi quả ớt hiểm bình thường chỉ đạt khoảng 5,000 đơn vị. Để có được giống ớt này, một nông dân chuyên trồng ớt ở nước Anh đã phải bỏ ra 5 năm để lai tạo các giống ớt từ Ấn Độ và vùng Caribbean.
5. Giống ớt đắt nhất thế giới

Trong những ngày vừa qua, cả thế giới đều tá hỏa khi biết đến sự tồn tại của những quả ớt đắt đỏ này. Loại ớt Charapita có giá lên đến 26,000USD/kg, (tương đương gần 600 triệu đồng tiền Việt Nam). Ớt Charapita có tên khoa học là Capsicum Baccatum, thuộc họ Solanaceae. Ớt này được trồng nhiều ở phía Bắc Peru, bắt nguồn từ một thành phố có tên Iquitos, người dân ở đây gọi loại ớt này là “Charapas” – một từ lóng chỉ trạng thái tâm lý thoải mái.

Sở dĩ loại ớt này có giá trị kinh tế cao như thế là vì ngoài hương vị đặc biệt, nó còn có giá trị rất cao về sức khỏe. Do chứa hàm lượng cao capsaicin nên ớt Charapita có thể giúp giảm đau, hỗ trợ tiêu hóa và chống viêm nhiễm. Lượng vitamin C trong mỗi quả ớt lên đến 76,4 mg (tương đương với một quả cam trọng lượng trung bình), đây là chất chống oxy hóa, giúp ngăn ngừa lão hóa, giảm lão hóa tế bào. Mỗi quả ớt Charapita chứa 428 IU vitamin A cần thiết để duy trì thị lực, khoảng 240mcg beta carotene, 319 mcg zeaxanthin, đều là những dưỡng chất có lợi cho đôi mắt, giúp ngăn ngừa thoái hóa điểm vàng.

![[Fun fact] Cây thông Noel và những điều bạn chưa từng biết tới Hình ảnh giáng sinh đẹp (Ảnh: Internet)](https://bloganchoi.com/wp-content/uploads/2020/12/giang-sinh-218x150.jpg)









Anh ơi, có thể cho xin ít hạt giống về trồng được không ạ. Xin cám ơn Anh. SĐT: 0913637335